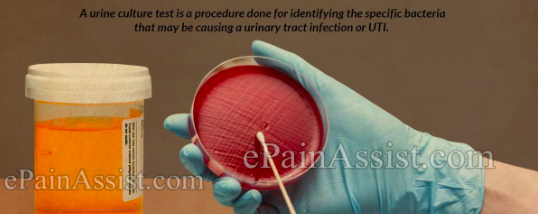

What are some clinical manifestations of hypomagnesiumia?
- Weakness
- Fatigue
- Muscle cramps
- Tetany
- Numbness
- Seizures
- Arrhythmias

Why do kidney’s get bigger in early diabetic neuropathy?
Hyperfiltration due to hyperglycaemia making the macula densa think GFR is low, so hypertrophy

What is the most common cause of nephrotic syndrome?
Adults: membranous GN
Child: minimal change disease
What is the likely diagnosis?

Minimal change disease
- Do a renal biopsy
- Urine dipstick
What is the most likely cause of this?

VASCULITIS
(could also be SLE)
What are the different types of upper and lower urinary tract infections?
- Pyelonephritis (kidney)
- Cystitis (bladder)
Most common cause of gram negative sepsis

What defence mechanisms do we have against UTIs?
- Vesico-ureteral valves
- Mucosal barries
- Acidic urine
- Emptying of bladder washing organisms
- Antibacterial/immunological secretions into urine

What are some risk factors for developing a UTI?
- Female: shorter urethra
- Neurological: incomplete emptying e.g MS, stroke
- Obstruction: pregnancy, stones, enlarged prostate, tumours
- Pregnancy: relaxation of muscle and obstruction
- DM and immunosupression
- Catheter
- Vesico-ureteric reflux (usually children)

What bacteria cause UTIs?
- Gram negative rods, especially coliforms like E.Coli
- Coagulase negative staphylococci e.g staph saprophyticus, in young women and hospitalised patients
- P.Aeruginosa and other gram negatives in hospital as antibioti selective pressure

What are e.coli’s virulence factors for a UTI?
- Flagella: movement
- Pili: attachement
- K antigen: colonisation

What is the clinical presentation of cystitis and pyelonephritis?

What are some other causes of dysuria apart from cystitis?
- STIs
- Post sexual intercourse
- Contact with irritants
- Symptoms of menopause and vaginal atrophy
What is the difference between a complicated and uncomplicated UTI?
Complicated there is at least one factor that predisposes a patient to persistent infection, recurrent infection or treatment failure, e.g structural abnormality

How should we collect a urine specimen?
- Midstream urine collection (hold labia open)
- Culture urine within 4 hours or refrigerate/boric acid preservative.
- Need to do all of this to prevent contamination
(collection bag, suprapubic aspiration, catheter sample)

When should you culture urine not just dipstick?
- Pregnancy
- Treatment failure
- Recurrent infections
- Suspected pyelonephritis
- Male
- Children
What can a urine dipstick check for?
- Leukocyte esterase
- Nitrites
- Blood
- pH
- Protein
Can be used in uncomplicated UTIs in under 65s but can’t be used for catheterised patients or over 65s

Who can we use the urine dipstick on?
- Remember to visual inspect the urine to see if pyuria
- Dipstick can help decide if antibiotics can be prescribed

What is screened for in the urine in the lab?
- White cells
- Red cells
- Squamous epithelial cells
All done by microscopy or culture. Significant bacteriuria is >105 cfu per mL of urine but need to interpret symptoms with this.

What are some causes of sterile pyruia (white cells in urine but no bacteria)?
- Prior antibiotics
- Urethritis e.g chlamydia
- Vaginal infection or inflammation
- Fastidious organisms
- Non infective inflammation e.g chemicals
- Urinary tuberculosis
What should we do if we suspect urinary tuberculosis?
Can’t culture like normal, need three early morning specimens. Really rare
How should we investigate a child presenting with a UTI?
Think about imaging the urinary tract as may have vesico ureteric reflux

What are some possible causes of ‘urethral syndrome’ (abacterial cystitis)?
- Infection with low counts of bacteria
- Infection with organisms not on routine culture
- STIs
- Non-infective inflammation
When do we screen for asymptomatic bacteriuria and why?
- Common in elderly and with catheters but only screened and tested in pregnancy as leads to high risk of premature labour and pyelonephritis
Apart from administering antibiotics, how can we manage a UTI?
- Increase fluid intake
- Analgesia e.g paracetamol
- Address underlying disorders e.g stones






